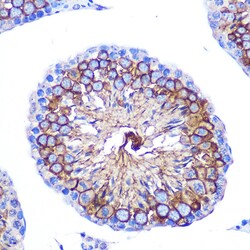
Invitrogen CD47 Polyclonal Antibody 100 &mu;L; Unconjugated:Antibodies,

missing translation for 'onlineSavingsMsg'
Learn More
Learn More
Invitrogen™ CD47 Polyclonal Antibody
Rabbit Polyclonal Antibody
Brand: Invitrogen™ PA5-116827
This item is not returnable.
View return policy
Description
Immunogen sequence: VASNQKTIQP PRK Positive Samples: MCF7, Jurkat, U-251MG, Mouse spleen, Mouse kidney, Rat kidney.
CD47, known as integrin-associated protein (IAP), is a glycosylated transmembrane glycoprotein with five domains, expressed widely across hematopoietic cells like T and B cells, monocytes, platelets, and erythrocytes, as well as non-hematopoietic cells. It interacts with integrins such as CD51/CD61 and CD41/CD61, and serves as a receptor for thrombospondin, mediating bi-directional signaling that affects neural synaptic activity and macrophage phagocytosis. CD47 acts as a ligand for CD172a (SIRP alpha), an inhibitory receptor on macrophages, preventing phagocytosis of CD47-positive cells. This interaction influences cell migration, B cell adhesion, T cell activation, and neuronal development, particularly in synapse-rich brain and retina regions. It also modulates chondrocyte responses to mechanical signals. T cell expression of CD47 can lead to activation or apoptosis in the presence of thrombospondin. Monoclonal antibody stimulation of CD47 has been shown to induce CD4+CD25- suppressive activity and increase Foxp3 expression. CD47's role in membrane transport, signal transduction, and its broad tissue distribution highlight its significance in various physiological processes.
Specifications
| CD47 | |
| Polyclonal | |
| Unconjugated | |
| CD47 | |
| 9130415E20Rik; AA407862; AI848868; antigen identified by monoclonal antibody 1D8; antigenic surface determinant protein OA3; AW108519; B430305P08Rik; Cd47; CD47 antigen; CD47 antigen (Rh-related antigen, integrin-associated signal transducer); CD47 antigen/integrin-associated protein; CD47 glycoprotein; CD47 molecule; CD47/IAP; IAP; integrin associated protein; integrin-associated protein; integrin-associated signal transducer; Itgp; Leukocyte surface antigen CD47; MER6; OA3; Protein MER6; Rh-related antigen; sCD47; soluble CD 47; soluble CD47 | |
| Rabbit | |
| Affinity chromatography | |
| RUO | |
| 16423, 961 | |
| -20°C, Avoid Freeze/Thaw Cycles | |
| Liquid |
| ELISA, Immunohistochemistry (Paraffin), Western Blot, Immunocytochemistry | |
| 1.53 mg/mL | |
| PBS with 50% glycerol and 0.09% sodium azide; pH 7.3 | |
| Q08722, Q61735 | |
| CD47 | |
| Synthetic peptide | |
| 100 μL | |
| Primary | |
| Human, Mouse, Rat, Rat | |
| Antibody | |
| IgG |
Product Content Correction
Your input is important to us. Please complete this form to provide feedback related to the content on this product.
Product Title
Spot an opportunity for improvement?Share a Content Correction